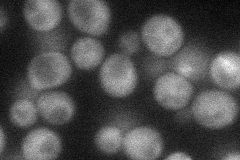
YLR099C
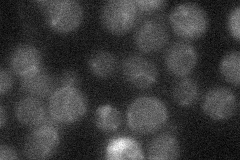
YLR099C
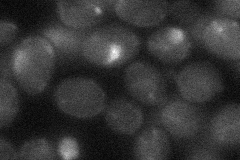
YLR099C
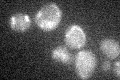
YLR099C
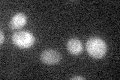
YLR099C

View description
Lysophosphatidic acid acyltransferase, responsible for enhanced phospholipid synthesis during organic solvent stress; null displays increased sensitivity to Calcofluor white; highly expressed during organic solvent stress
Localization:
Intensity:
Fold change:
Significance:
-
C’ GFP library in SD

below threshold17.36 -
N' NOP1pr-GFP in SD
cytosol34.7559 -
N' TEF2pr-mCherry in SD

below threshold13.4796 -
N' NATIVEpr-GFP in SD
below threshold20.0345 -
N' TEF2pr-VC and Cyto-VN in SD
below threshold24.4254 -
C’ GFP library in SD+DTT

cytosol16.950.97No -
C’ GFP library in SD+H2O2
cytosol17.150.98No -
C’ GFP library in Starvation Media
cytosol26.21.5No -
C’ GFP library on the background of Pup2-DaMP

below threshold -
C’ GFP library on the background of CCT mutant

below threshold17.61091.01429No
